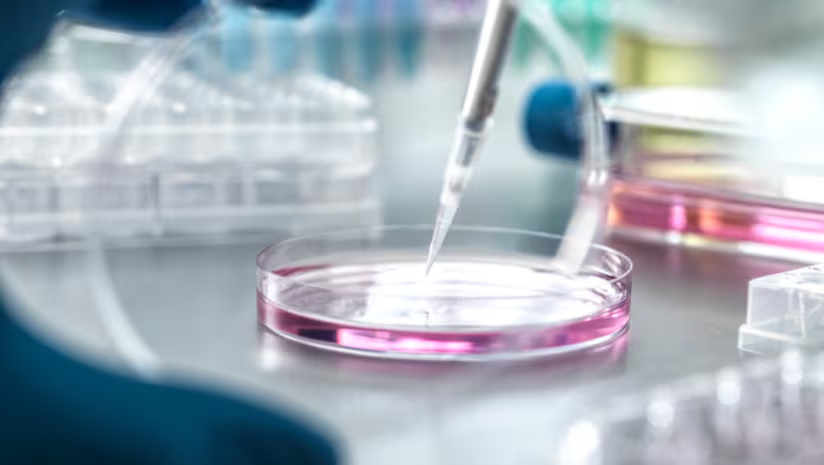
See new findings on collagen for wrinkles and knee pain reduction, nicotinamide mononucleotide's (NMN) reported benefits in increasing hair length growth at the anagen phase and more in this research news round-up.
#nmn #hair #collagen
nutraingredients.com/Article/2025/1…

NutraIngredients Asia
@nutraasia
Breaking news, insights and opinion about nutrition, health and dietary supplements in Asia Pacific. Check out our sister title @FoodNavAsia too!
ID: 720877186916311040
http://www.nutraingredients-asia.com/ 15-04-2016 07:31:29
6,6K Tweet
1,1K Takipçi
250 Takip Edilen